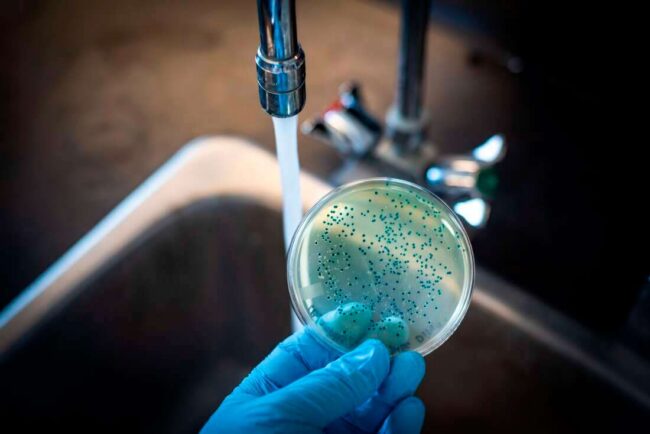
Холера поддается лечению, а вакцинация предотвращает заражение. Фото.

История нашего вида – это история войны. Мы, люди, все время сражаемся друг с другом, но нашим главным врагом являются вирусы и бактерии. Именно болезни, а не полководцы и императоры, определяли ход истории. Так, Атилла, Александр Македонский и Чингисхан пали жертвами малярии, переносчиками которой были комары. Римская империя также обязана этим маленьким насекомым, которые покусали их заклятого врага Ганнибала и немалую часть его армии. Во время Первой мировой войны грипп и пневмония унесли намного больше жизней, чем все боевые действия. История вновь показывает нам неприятную правду: одна-единственная желудочная инфекция, грипп, дизентерия или холера, могут остановить целую армию, не сделав ни единого выстрела.

Холера под микроскопом
Содержание
Болезни и конфликты
Научный прогресс привел человечество к победе над самыми страшными болезнями. Эта победа позволила нам стать доминирующим видом живых существ на планете, а в обозримом будущем на свет появится восьми миллиардный житель Земли. За это время мы привыкли к комфорту и размеренной жизни, да так, что огромное количество людей в мире не доверяет ни ученым, ни созданным ими вакцинам и лекарствам.
На самом деле на нашей планете нет и не было ни единого дня без военных действий – трава у соседа, видимо, всегда зеленее. Но там, где люди сражаются друг с другом, в игру вступает третья сила. Разрушение городов во время военных действий превращает территорию в настоящий рассадник всевозможных инфекций. Отсутствие инфраструктуры и загрязнение окружающей среды выпускают на волю наших невидимых врагов.

Бактерии и вирусы представляют серьезную угрозу по всему миру
Плохая циркуляция воздуха в помещениях, антисанитария, нехватка питьевой воды (необходимой в том числе для мытья) и ограниченный доступ к средствам гигиены и оборудованию могут привести к самой настоящей гуманитарной катастрофе.
Однако военный конфликт далеко не всегда становится причиной вспышки смертельных болезней. Река Ганг в Индии, например, считается местом рождения дизентерии, холеры и прочих болячек, столкнуться с которыми не хочет никто.
Так как пандемия COVID-19 не собирается отступать, она напомнила изумленной публике о необходимости мытья рук, дезинфекции поверхностей, защитных масках и соблюдении социальной дистанции. Все эти рекомендации жителям мегаполисов выполнить не сложно, при условии, что у них есть доступ к чистой воде и средствам гигиены. В противном случае риск распространения инфекций, о которых мы вспоминаем в основном на уроках истории, возрастает.
О том, как и почему переносчики малярии изменили ход истории, можно прочитать здесь. Знания – всему голова.
Портрет убийцы – холера
Среди болезней, регулярно циркулирующих на планете, холера занимает особое место. Так, ранее в этом году в Карачи был зарегистрирован беспрецедентный рост заражения холерой, в результате которого сотни детей и взрослых попали в больницы. Да что уж там, вспышки холеры в разных регионах планеты происходят на протяжении всей нашей истории.
Холера – острая диарейная инфекция, вызванная приемом пищи или воды, загрязненной бактерией Vibrio cholerae. Эта болезнь является угрозой общественному здравоохранению и в XXI веке. Исследователи отмечают, что вспышки холеры также свидетельствуют о неравенстве и отсутствии социального развития.

Холера представляет серьезную угрозу мировому здравоохранению
По оценкам специалистов, в мире ежегодно происходит от 1,3 до 4,0 млн случаев заболевания холерой и 21 000–143 000 случаев смерти от холеры, – говорится на сайте Всемирной организации здравоохранения (ВОЗ)
Будучи чрезвычайно опасным и заразным заболеванием, холера вызывает острую диарею. Бактерия Vibrio cholerae поражает детей и взрослых, а самая большая ее опасность – это смерть в течение нескольких часов после заражения. Смерть наступает если больному не было оказано никакого лечения.
Еще больше интересных статей об опасных инфекциях можно прочитать на нашем канале в Яндекс.Дзен – там регулярно выходят статьи, которых нет на сайте
Симптомы холеры
Итак, у большинства зараженных холерой не развивается никаких симптомов, хотя бактерии присутствуют в фекалиях в течение 1-10 дней после заражения. Когда они попадают обратно в окружающую среду, то потенциально могут заражать все больше и больше людей.
Оказавшись в организме человека, бактерия Vibrio cholerae проявляется в виде легких или умеренных симптомов. В то же самое время у небольшого процента зараженных развивается острая форма диареи и сильное обезвоживание. Если не предпринимать никаких действий, смерть неизбежна.

Изучение инфекционных болезней и патогенов – важнейшая профилактика возможных эпидемий
Интересный факт
В 19 веке холера распространилась по всему миру из своего первоначального резервуара в дельте реки Ганг в Индии. Шесть последующих пандемий унесли жизни миллионов человек на всех континентах.
Симптомы холеры включают в себя диарею, не прекращающуюся рвоту, мышечные судороги, цианоз, мучительную жажду, головную боль и цианоз. Инкубационный (скрытый) период может составлять от нескольких часов до 5 дней, чаще 1-2 суток. Во многих случаях болезнь начинается остро и требует неотложной помощи.
Лечение и профилактика холеры
В конце апреля Роспотребнадзор рекомендовал регионам усилить меры профилактики для предотвращения завоза и распространения холеры в Россию. К счастью, современные препараты эффективно действуют на холерный вибрион, а терапия способствует профилактике осложнений. Лучшим средством профилактики холеры является вакцинация.
По данным ВОЗ защититься от холеры позволяет кипяченая вода, фильтрованная вода и бутилированная вода. Чистую обеззараженную воду необходимо использовать для питья, приготовления пищи и льда, гигиенических процедур и мытья посуды.

Доступ к чистой воде и продуктам питания, наравне с правилами гигиены является наилучшей профилактикой не только холеры, но и других кишечных инфекций
Чтобы обеззаразить загрязненную воду, ее необходимо прокипятить в течение одной минуты (или 3 минут при более высокой температуре), подвергнуть фильтрации или обеззаразить с помощью химических или реагентных методов (к ним относится введение сильных окислителей, в качестве которых используют хлор, диоксид хлора, озон, иод, гипохлорит натрия и кальция, перекись водорода, марганцевокислый калий). Эксперты также советуют избегать сырых продуктов, например, неочищенных овощей и фруктов, сырое или недоваренное мясо, а также непастеризованное молоко и молочные продукты.
Недавно мой коллега Рамис Ганиев рассказывал о вспышке «плотоядной болезни» в США. Узнать насколько она опасна и почему бактерии пожирают плоть, можно здесь.
Но что делать, если вы заразились? К счастью, холера хорошо поддается лечению, но поскольку обезвоживание может произойти быстро, лечение необходимо начать немедленно.
Основным лечением является гидратация.
В зависимости от тяжести симптомов, лечение будет состоять из пероральных или внутривенных растворов для восполнения потерянной жидкости. При этом антибиотики не являются частью неотложной помощи в случае легкого течения болезни, – отмечают специалисты.
Холера поддается лечению, а вакцинация предотвращает заражение
Если резюмировать вышеописанное, то главной мерой профилактики холеры является строгое соблюдение гигиены и изоляции больного. Все лица, контактирующие с зараженным, наблюдаются в течение 5-ти дней. Будьте здоровы, берегите себя и близких и тщательно мойте руки. Cоблюдение правил гигиены убережет вас не только от холеры и кишечных инфекций, но и от COVID-19.



Новости, статьи и анонсы публикаций
Чат с читателямиСвободное общение и обсуждение материалов